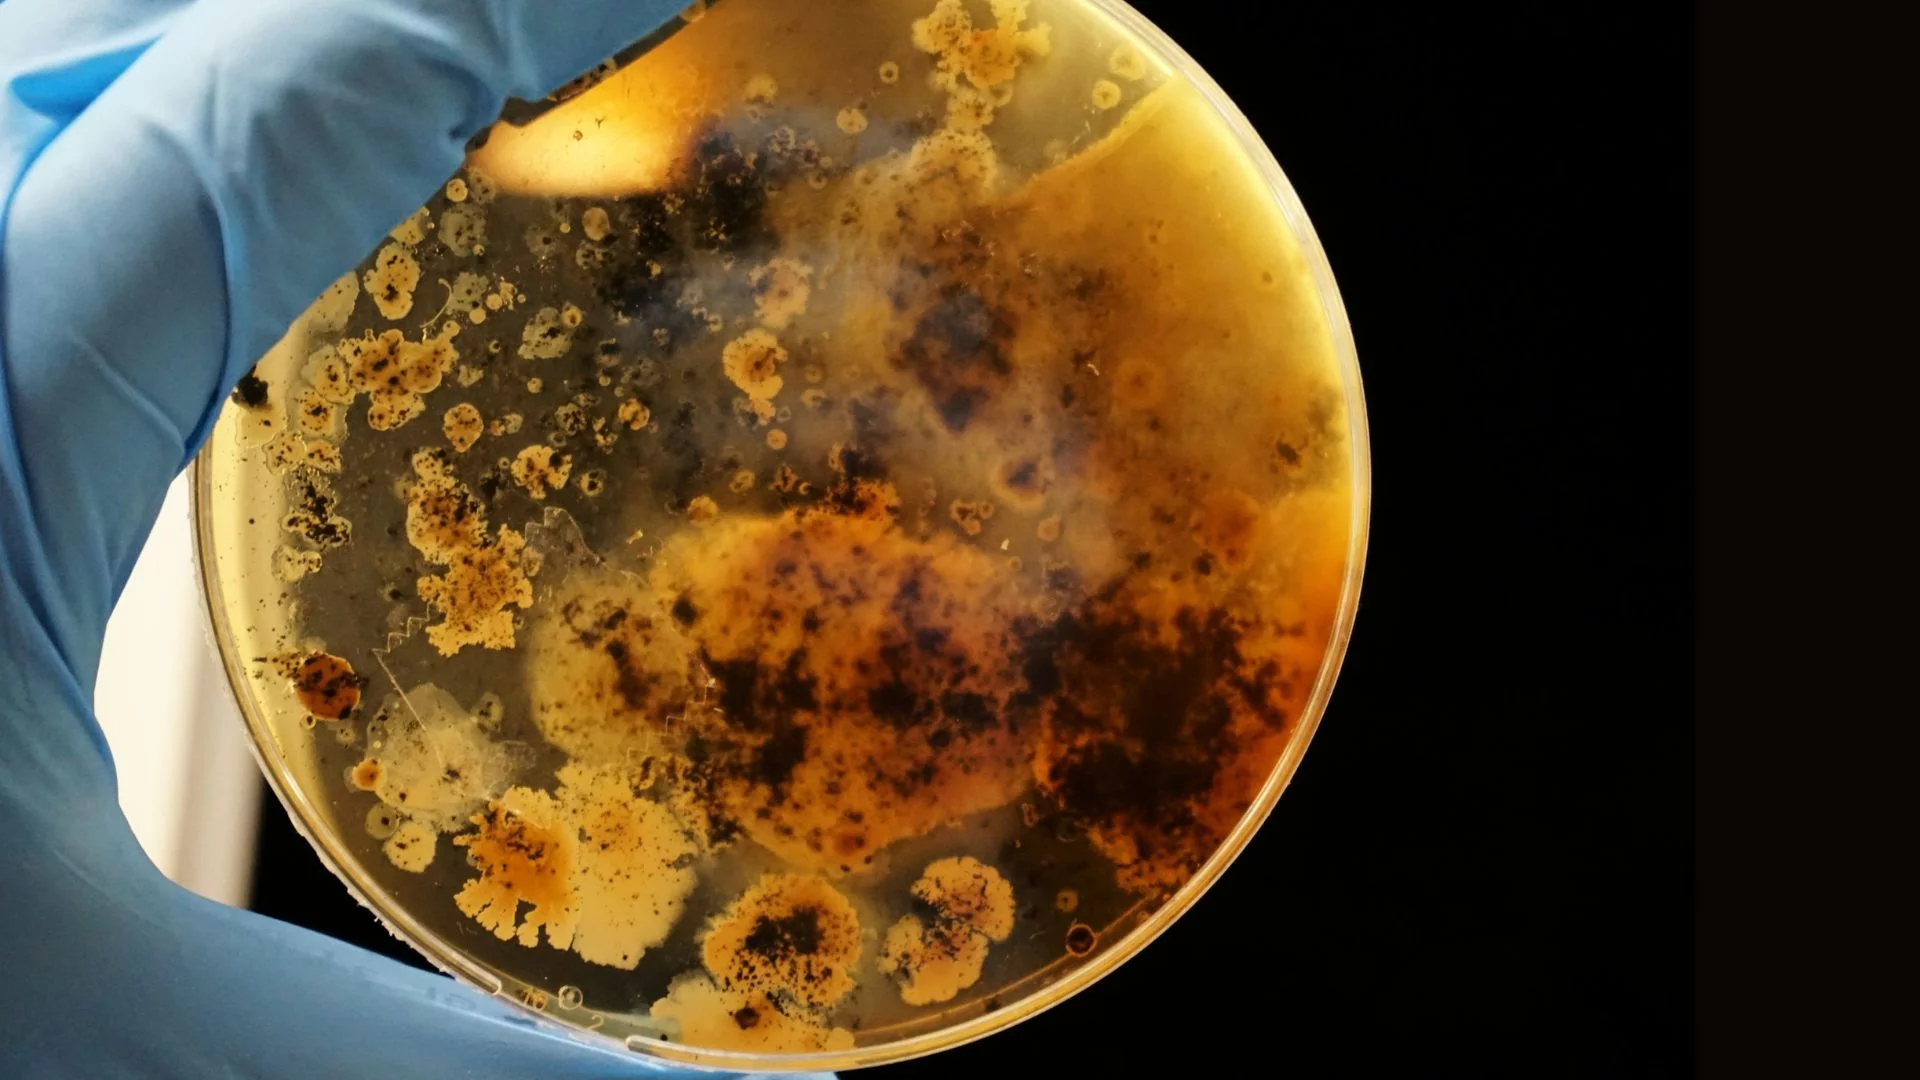
Bakterie są coraz bardziej odporne na leki, ostrzega WHO.

Światowa Organizacja Zdrowia ostrzega w dwóch nowych raportach: oporność mikroorganizmów na leki przeciwbakteryjne stanowi coraz większe zagrożenie dla ludzkości, a sposób, w jaki rozwijane są nowe antybiotyki, nie nadąża za kryzysem. Według prognoz WHO, w ciągu najbliższych 25 lat oporność na antybiotyki może doprowadzić do 39 milionów zgonów na całym świecie, informuje magazyn "Nature".
Raporty WHO wskazują na dwa zasadnicze problemy. Po pierwsze, niewielką liczbę nowych leków w fazie badań klinicznych. Po drugie, brak innowacji w metodach zwalczania drobnoustrojów odpornych na leczenie. Analizy danych pokazują, że w wielu regionach dotychczasowe strategie, takie jak kampanie edukacyjne, czy zmniejszanie niepotrzebnego stosowania antybiotyków, nie wystarczają.
Jak zwykłe infekcje mogą stać się śmiertelne
Zdaniem ekspertów kluczowe znaczenie mają działania obejmujące wspieranie badań nad nowymi mechanizmami działania leków oraz rozwój diagnostyki pozwalającej szybko dobierać skuteczne leki. Bez takich kroków odporność mikroorganizmów może doprowadzić do sytuacji, w której zwykła infekcja stanie się śmiertelna – scenariusza, który eksperci nazywają "bakteriami z koszmaru" (nightmare bacteria).
"Oporność na środki przeciwdrobnoustrojowe narasta, a liczba nowych terapii i metod diagnostycznych jest zbyt mała, by powstrzymać rozprzestrzenianie się zakażeń bakteriami opornymi na leki" – powiedziała Yukiko Nakatani, zastępczyni dyrektora generalnego WHO ds. systemów zdrowotnych w Genewie, cytowana przez "Nature".
Najgroźniejsze infekcje u ludzi często wywołują tzw. bakterie gram-ujemne. Jest to grupa drobnoustrojów, które wyróżniają się szczególnie silną odpornością na antybiotyki. Do tej grupy należą m.in. E. coli (częsta przyczyna zakażeń układu moczowego i sepsy) oraz Acinetobacter baumannii (często występujący w szpitalach, zwłaszcza na oddziałach intensywnej terapii).
Dlaczego bakterie stają się odporne na leczenie?
Rosnąca oporność bakterii na antybiotyki to jeden z najpoważniejszych problemów zdrowia publicznego. Jego główną przyczyną jest nadużywanie i niewłaściwe stosowanie antybiotyków. Są one często przepisywane na infekcje wirusowe, wobec których są nieskuteczne, lub przyjmowane zbyt krótko, co pozwala przetrwać najbardziej odpornym bakteriom.
Zjawisko to potęguje także masowe stosowanie antybiotyków w rolnictwie i hodowli zwierząt – nie tylko w leczeniu chorób, ale również w celu przyspieszania wzrostu, co sprzyja powstawaniu i rozprzestrzenianiu się odpornych szczepów.
Kolejnym czynnikiem jest zanieczyszczenie środowiska farmaceutykami. Odpady z produkcji leków oraz niezużyte antybiotyki trafiają do ścieków, wód gruntowych i gleby. W takich warunkach bakterie mają stały kontakt z niskimi stężeniami substancji bakteriobójczych, ucząc się mechanizmów przetrwania i przekazując geny oporności innym mikroorganizmom.
Trzecim, często pomijanym elementem, na który szczególna uwagę zwraca WHO w ostatnich raportach, jest brak nowych terapii i skutecznych narzędzi diagnostycznych. Od dekad na rynek trafia bardzo niewiele nowych klas antybiotyków, ponieważ ich opracowanie jest kosztowne i mało opłacalne dla koncernów farmaceutycznych.
Zobacz także






